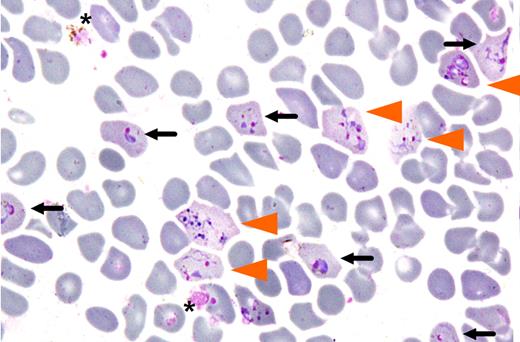
Invasion of enrinched reticulocyte population by Plasmodium vivax. Cells invaded by either one (black arrow) or multiple merozoites (orange arrowhead) after 24 hours of in vitro culture are shown (from Figure 5 of Russell et al1).

The lack of availability of a reliable assay system for culturing of Plasmodium vivax parasites ex vivo has been a major impediment to furthering our understanding of an important human parasitic disease. In this issue of Blood, Russell and colleagues outline an ex vivo invasion assay of human reticulocytes by P vivax.1
Pvivax malaria is a far from trivial problem. Although less lethal than its close relative, P falciparum, P vivax infects some 400 million people annually, mainly in Asia and South America.2,3 Recent studies suggest that the mortality of the disease and its effects on health may have been seriously underestimated.2,4
If P vivax has not enjoyed the kind of celebrity attention that malariologists have accorded to P falciparum, this is mainly because it has up to now resisted all efforts to culture it in vitro. Indeed, the extensive progress that the past 3 decades have seen in our grasp of the pathobiology of P falciparum–infected red cells and of the role that they play in clinical manifestations of the disease can in large mea-sure be traced back to the development by Trager and Jensen in 1976 of an in vitro system for culturing these parasites in human red cells.5 Strenuous attempts in the 1980s to establish a similar experimental culture system for P vivax met with only limited success. Now Russell and colleagues have gone some way to making good the deficiency.1
Based on the knowledge that the P vivax merozoite has a strong preference for reticulocytes, the present study outlines a standardized protocol for routine culturing of P vivax. This ex vivo experimental system makes use of reticulocytes isolated from cord blood to induce invasion. Russell and colleagues achieved invasion by this means with parasites derived from 85 patients (see figure). While the re-ported assay system is a notable advance, it still has a number of drawbacks; these include the necessity to perform invasion assays with freshly isolated infected blood samples, and the variable efficiency of the resulting invasion. One may anticipate that further optimization of the experimental system will overcome these deficiencies.
Invasion of enrinched reticulocyte population by Plasmodium vivax. Cells invaded by either one (black arrow) or multiple merozoites (orange arrowhead) after 24 hours of in vitro culture are shown (from Figure 5 of Russell et al1 ).
Invasion of enrinched reticulocyte population by Plasmodium vivax. Cells invaded by either one (black arrow) or multiple merozoites (orange arrowhead) after 24 hours of in vitro culture are shown (from Figure 5 of Russell et al1 ).
What, then, will be the impact of these findings? One key value of a reliable assay system would be to permit screening of candidate vaccines against P vivax. Secondly, the assay should prove useful in the study of membrane and cellular changes induced in P vivax–infected red cells. Recent studies have revealed that certain strains of the parasite can invade red cells deficient in Duffy antigen,6 the only red cell receptor previously implicated in invasion; as in the case of P falciparum therefore, the in vitro culture system should lead to the identification of red cell receptors, other than Duffy antigen, that may be involved in P vivax invasion. More generally, the new experimental system promises a new route toward a better description of the physiologic and pathologic mechanisms of P vivax infection.
Conflict-of-interest disclosure: The author declares no competing financial interests. ■